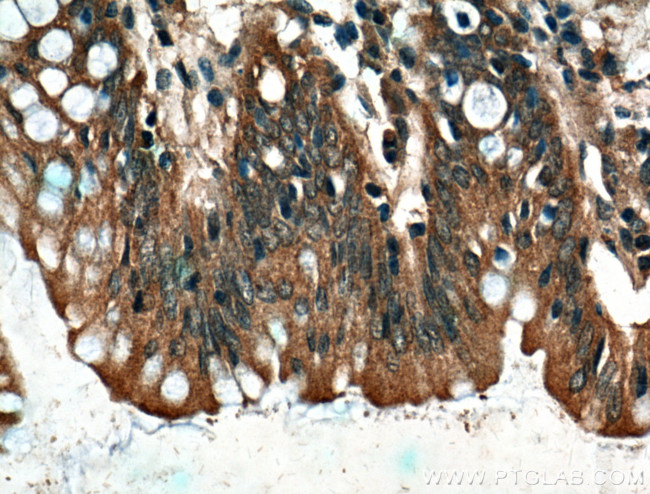
CARMIL Antibody in Immunohistochemistry (Paraffin) (IHC (P))

Search
Proteintech
CARMIL Polyclonal Antibody
{{$productOrderCtrl.translations['antibody.pdp.commerceCard.promotion.promotions']}}
{{$productOrderCtrl.translations['antibody.pdp.commerceCard.promotion.viewpromo']}}
{{$productOrderCtrl.translations['antibody.pdp.commerceCard.promotion.promocode']}}: {{promo.promoCode}} {{promo.promoTitle}} {{promo.promoDescription}}. {{$productOrderCtrl.translations['antibody.pdp.commerceCard.promotion.learnmore']}}
产品信息
27133-1-AP
种属反应
宿主/亚型
分类
类型
抗原
偶联物
形式
浓度
规格
纯化类型
保存液
内含物
保存条件
运输条件
产品详细信息
Immunogen sequence: RVDEGVDEF FTKKVTKMDS KKWSTRGSES HELNEGGDEK KKRDSRKSSG FLNLIKSRSK SERPPTILMT EEPSSPKGAV RSPPVDCPRK DTKAAEHNGN SERIEEIKTP DSFEESQGEE IGKVERSDSK SSPQAGRRYG VQVMGSGLLA EMKAKQEKRA ACAQKKLGND AVSQDSSSPA LSSVERSDGG GAGLPENRFG LGTPEKNTKA EPKAEAGSRS RSSSSTPTSP KPLLQSPKPS LAARPVIPQK PRTASRPDDI PDSPSSPKVA LLPPVLKKVP SDKERDGQSS PQPSPRTFSQ EVSRRSWGQQ AQEYQEQKQR SSSKDGHQGS KSNDSGEEAE KEFIFV (1021-1365 aa encoded by BC140770)
靶标信息
Cell membrane-cytoskeleton-associated protein that plays a role in the regulation of actin polymerization at the barbed end of actin filaments. Prevents F-actin heterodimeric capping protein (CP) activity at the leading edges of migrating cells, and hence generates uncapped barbed ends and enhances actin polymerization, however, seems unable to nucleate filaments (PubMed:16054028). Plays a role in lamellipodial protrusion formations and cell migration (PubMed:19846667). [UniProt]
仅用于科研。不用于诊断过程。未经明确授权不得转售。
篇参考文献 (0)
生物信息学
蛋白别名: Capping protein regulator and myosin 1 linker protein 1; Capping protein, Arp2/3 and myosin-I linker homolog 1; Capping protein, Arp2/3 and myosin-I linker protein 1; capping protein, Arp2/3, and Myosin-I Linker homolog 1; CARMIL homolog; cytoskeleton protein; F-actin-uncapping protein LRRC16A; leucine rich repeat containing 16; leucine rich repeat containing 16A; Leucine-rich repeat-containing protein 16A; testicular tissue protein Li 107; unnamed protein product
基因别名: CARMIL; CARMIL1; CARMIL1a; dJ501N12.1; dJ501N12.5; LRRC16; LRRC16A
UniProt ID: (Human) Q5VZK9
Entrez Gene ID: (Human) 55604